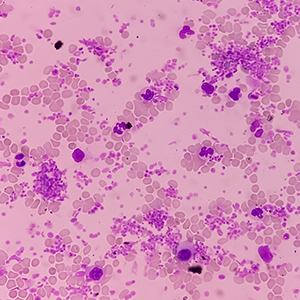
Thrombocytosis
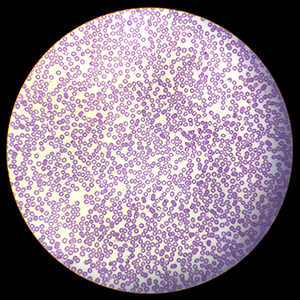
Pancytopenia
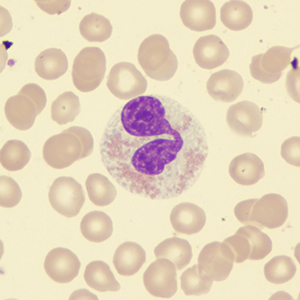
Myelodysplastic syndrome
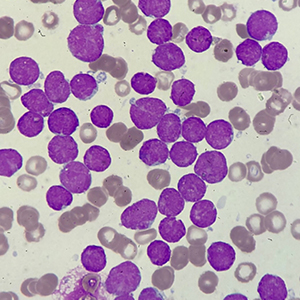
b-all

Can Immunotherapy Eliminate Rectal Cancer?
For many years, rectal cancer treatment followed a standard approach that usually involved surgery, chemotherapy, and radiation therapy Read More

For many years, rectal cancer treatment followed a standard approach that usually involved surgery, chemotherapy, and radiation therapy Read More

Advanced Precision Endometrial Cancer Care in Vijayawada Read More

Precision-Based Cancer Care: Advanced Surgery, Medical Oncology, NGS, and Personalized Treatment Strategies Read More

Revolutionizing Colon Cancer Care: The Role of Advanced Surgery, Precision Oncology, NGS, and Personalized Treatment Approaches Read More

State-of-the-Art DEXA Assessment for Bone Health and Body Composition. One Simple Scan. Valuable Insights into Bone Strength, Read More

After successful colon cancer surgery, scans may appear normal. But an important question remains: Read More

For many women diagnosed with endometrial (uterine) cancer, surgery is often the Read More

A low platelet count, clinically referred to as thrombocytopenia, occurs when the number of platelets in the blood Read More

A white blood cell (WBC) count is a blood test that determines how many white blood cells are present in the circulating blood. Read More

Low hemoglobin levels indicate a reduced capacity of the blood to transport oxygen to tissues, a condition Read More

Sarcoma is a type of cancer that begins in the bones or soft tissues like muscles, fat, blood vessels, nerves, or deep skin tissues. Although it is less Read More

Oral cancer is a serious disease that affects the mouth, including the lips, tongue, cheeks, floor of the mouth, palate, and throat. It usually begins as a small, Read More

Kidney cancer is a type of cancer that begins in the kidneys, which are two bean-shaped organs located on either side of your spine, just below Read More

Brain cancer is a serious disease that affects many people worldwide. It occurs when abnormal cells grow uncontrollably in the brain, forming a Read More

Skin cancer is one of the most common types of cancer worldwide. It occurs when skin cells grow abnormally due to damage from exposure Read More
Cancer is a complex group of diseases characterized by the uncontrolled Read More


Breast cancer remains one of the most common and alarming health concerns affecting women worldwide. It is a malignant tumor that originates Read More
A liquid biopsy is a minimally invasive diagnostic procedure that identifies cancerous cells by analyzing fragments released into the bloodstream Read More

Thrombocytosis is a condition where you have a higher-than-normal number of platelets in your blood, which are cells that help with clotting. It is classified as Read More
Thrombocytopenia is a medical condition where your blood has an abnormally low number of platelets (thrombocytes), which are essential for blood clotting Read More


Splenomegaly is the medical term for an enlarged spleen, often found during a routine physical exam and sometimes causing symptoms like abdominal Read More
Neutropenia is a condition where your body doesn't have enough neutrophils, a type of white blood cell that fights infection. Having too few neutrophils makes Read More

Pancytopenia is a condition where blood tests show low levels of all three main types of blood cells: red blood cells (anemia), white blood cells (leukopenia), Read More
NHL (Non-Hodgkin Lymphoma) is a diverse group of blood cancers that arise from lymphocytes, or white blood cells, and affect the lymphatic Read More


Neutropenia is a condition where your body doesn't have enough neutrophils, a type of white blood cell that fights infection. Having too few neutrophils makes Read More
Myelodysplastic syndrome (MDS) is a group of blood cancers where blood stem cells in the bone marrow don't mature into healthy blood cells. This results in a shortage Read More

Multiple myeloma is a cancer of plasma cells in the bone marrow that leads to the uncontrolled growth of abnormal plasma cells, which can Read More
HL, or Hodgkin lymphoma, is a cancer of the lymphatic system characterized by the presence of large, abnormal Reed-Sternberg cells. It commonly Read More


An elevated white blood cell (WBC) count, known as leukocytosis, indicates the body is producing more white blood cells than normal, Read More
A bone marrow transplant is a medical procedure to replace diseased or damaged bone marrow with healthy stem cells, which are the cells that Read More

B-ALL, or B-cell acute lymphoblastic leukemia, is a fast-growing blood cancer where too many immature B-lymphocyte Read More
Anemia is a medical condition where the body does not have enough healthy red blood cells or hemoglobin to carry adequate oxygen to the body's tissues . Read More


Acute myeloid leukemia (AML) is a rapidly progressive cancer of the blood and bone marrow characterized by the overproduction of immature, abnormal Read More